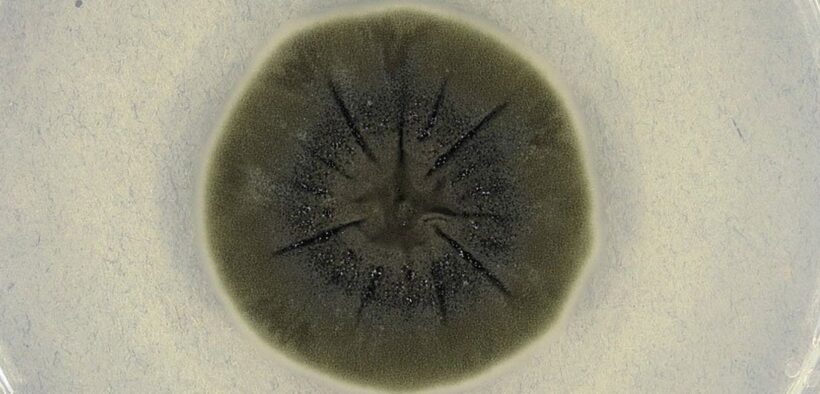
ჩერნობილში აღმოჩენილმა სოკომ მუტაცია განიცადა და ბირთვული რადიაცია მოიხმარა

ჩერნობილში აღმოჩენილმა სოკომ მუტაცია განიცადა და ბირთვული რადიაცია მოიხმარა
1986 წლის ჩერნობილის კატასტროფის შემდეგ, მეცნიერებმა შენიშნეს, რომ სოკოები იზრდებოდნენ რეაქტორის შიგნით, სადაც ძლიერი რადიაცია იყო. ერთ-ერთი ასეთი სახეობა იყო Cladosporium sphaerospermum, შავი სოკო, რომელიც შეიცავს მელანინის მაღალ რაოდენობას.
2007 წელს ნიუ-იორკის ალბერტ აინშტაინის სამედიცინო კოლეჯის მკვლევრებმა (Dadachova et al.) აჩვენეს, რომ ამ სოკოს შეუძლია: შთანთქოს იონიზირებული რადიაცია, და გარდაქმნას იგი ქიმიურ ენერგიად — პროცესი, რომელსაც მათ უწოდეს რადიოსინთეზი. ეს ძალიან ჰგავს ფოტოსინთეზს, ოღონდ ენერგიის წყარო აქ სინათლის ნაცვლად რადიაციაა.
2020 წელს, სოკო C. sphaerospermum გაგზავნეს საერთაშორისო კოსმოსურ სადგურზე.იქ ჩატარებულმა ექსპერიმენტმა აჩვენა, რომ სოკოს ფენა (~1.7 მმ სისქის) შეძლებდა დაახლოებით 2%-ით შეემცირებინა კოსმოსური რადიაცია.
პროექტი განხორციელდა NASA-ისგან მხარდაჭერილი iGEM-ის სტუდენტური გუნდის მიერ (Space Melanin Experiment).
პოტენციური გამოყენება:
ბირთვული ნარჩენების ლოკაციების ბიოდეგრადაცია;
მარსის ან სხვა პლანეტური ბაზების რადიაციული დაცვა;
ბიოლოგიური მასალების შემუშავება, რომლებიც “სწავლობენ” ენერგიის გამოყენებას რადიაციიდან.


















